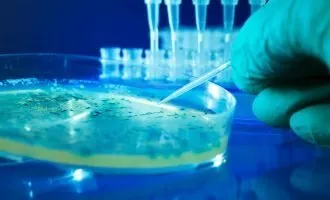

ژنتیک
آخرین مطالب (صفحه 6)
-
علمی محققان یک گام دیگر به درمان ناشنوایی مادرزادی با ژن درمانی نزدیکتر شدند
محققان دانشگاه ایالتی اورگان گام بزرگی در جهت حل معمای استفاده از ژن درمانی برای بازیابی شنوایی افراد ناشنوا برداشتند و به نتایج امیدوار کنندهای ...
![]() ۳۱ اردیبهشت ۱۴۰۰
۳۱ اردیبهشت ۱۴۰۰
-
علمی دانشمندان با پژوهش جدیدی دلیل عمر طولانی برخی افراد را مشخص کردند
محققان بر اساس پژوهش جدیدی دریافتهاند افرادی که بیش از ۱۰۵ سال عمر میکنند، از منشا ژنتیکی منحصر به فردی برخوردارند که باعث میشود بدن ...
![]() ۱۹ اردیبهشت ۱۴۰۰
۱۹ اردیبهشت ۱۴۰۰
-
علمی شرکت اوکسیتک پشههای اصلاح شده ژنتیکی را در آمریکا رها کرد
شرکت بیوتکنولوژی اوکسیتک پشههایی را به روش اصلاح شده ژنتیکی پرورش داده و میتوانند پشههای ناقل بیماریهایی مانند مالاریا را از بین ببرند، در فلوریدار ...
![]() ۱۶ اردیبهشت ۱۴۰۰
۱۶ اردیبهشت ۱۴۰۰
-
علمی دانشمندان هاروارد ابزار ویرایش ژنوم جدیدی برای رقابت با کریسپر خلق کردند
پژوهشگران موسسه Wyss هاروارد موفق به خلق ابزار ویرایش ژنوم جدیدی شدهاند که دانشمندان به وسیله آن میتوانند بطور همزمان میلیونها آزمایش ژنتیکی انجام دهند. ...
![]() ۱۲ اردیبهشت ۱۴۰۰
۱۲ اردیبهشت ۱۴۰۰
-
تکنولوژی بنیاد بیل گیتس بار دیگر با کمک مالی، از پروژه ریشه کن کردن مالاریا حمایت کرد
شرکت بیوتکنولوژی «اکسیتک» در پروژهای با هدف ریشه کن کردن پشههایی که میتوانند بیماریهایی مانند مالاریا و تب دانگ را منتقل کنند، تصمیم دارد تا ...
![]() ۱۰ اردیبهشت ۱۴۰۰
۱۰ اردیبهشت ۱۴۰۰
-
علمی دانشمندان با اصلاح ژنتیکی پشهها میخواهند با بیماری مالاریا مقابله کنند
مالاریا یکی از بیماریهای خطرناکی است که توسط انگل و نوع خاصی از پشه که از انسانها تغذیه میکند، به وجود میآید. پژوهشگران اخیرا برای ...
![]() ۲۹ فروردین ۱۴۰۰
۲۹ فروردین ۱۴۰۰
-
علمی محققان به دستاوردهای جدیدی برای درمان نابینایی با روش ژن درمانی دست یافتند
محققان دانشگاه پنسیلوانیا با استفاده از روش ژن درمانی مبتنی بر RNA به روش جدیدی برای بهبود بینایی بیماران مبتلا به بیماری «لبر (LCA) آموروزیس» ...
![]() ۱۳ فروردین ۱۴۰۰
۱۳ فروردین ۱۴۰۰
-
علمی دانشمندان برای اولین بار سلول مصنوعی با قابلیت تقسیم و رشد خلق کردند
برای اولین بار تیمی از دانشمندان موفق به خلق یک ارگانیسم تک سلولی یا سلول مصنوعی شدند که میتواند مشابه یک سلول زنده تقسیم شود و ...
![]() ۱۱ فروردین ۱۴۰۰
۱۱ فروردین ۱۴۰۰
-
علمی محققان با دستکاری ژنها توانستهاند دردهای مزمن را تسکین بدهند
گروهی از محققان دانشگاه کالیفرنیا، سن دیگو به روشی دست پیدا کردهاند که با دستکاری موقتی ژنها میتواند دردهای مزمن را کاهش دهد. این دستکاری ...
![]() ۲۳ اسفند ۱۳۹۹
۲۳ اسفند ۱۳۹۹
-
علمی تحقیق جدید از شباهت غیرمنتظره انسان با جانداری از ۵۵۰ میلیون سال قبل خبر میدهد
نیم میلیارد سال قبل، موجوداتی بدون سر و اندام در بستر اقیانوسها زندگی میکردند که حتی تصور شباهت داشتن آنها با انسان نیز غیرممکن است. ...
![]() ۲۰ اسفند ۱۳۹۹
۲۰ اسفند ۱۳۹۹
-
علمی ابزار مبتنی بر هوش مصنوعی انویدیا و هاروارد به تحلیل ژنوم سرعت میبخشد
محققان انویدیا و هاروارد از نوعی جعبه ابزار مبتنی بر یادگیری ماشینی به نام AtacWorks رونمایی کردند. این ابزار به منظور کاهش هزینه و مدت ...
![]() ۱۸ اسفند ۱۳۹۹
۱۸ اسفند ۱۳۹۹
-
علمی محققان ۶۴ ژنوم کامل انسان را به منظور درک بهتر تنوع ژنتیکی توالییابی کردند
محققان دانشکده پزشکی دانشگاه مریلند با انجام تحقیقی جدید موفق شدند ۶۴ ژنوم کامل انسان را توالییابی کنند تا به درک بهتری از تنوع ژنتیکی ...
![]() ۱۱ اسفند ۱۳۹۹
۱۱ اسفند ۱۳۹۹
-
علمی افرادی که سرما را دوست دارند احتمالا دارای نوعی جهش ژنتیکی هستند
اگر شما هم از جمله کسانی هستید که در سرمای زمستان لباس نازک میپوشند، شنا میکنند یا راحتتر از بقیه میتوانند در این فصل در ...
![]() ۱۰ اسفند ۱۳۹۹
۱۰ اسفند ۱۳۹۹
-
علمی محققان برخی سلولهای بدن را برای مبارزه با سرطان به «ابر سرباز» تبدیل کردند
محققان موفق شدند برخی گلبولهای سفید بدن را به «ابر سرباز» تبدیل کرده و از آنها برای تقویت یک پاسخ ضد تومور استفاده کنند. محققان ...
![]() ۳ اسفند ۱۳۹۹
۳ اسفند ۱۳۹۹
-
علمی محققان علت مقاومت خارقالعاده فیلها در برابر ابتلا به سرطان را کشف کردند
محققان علت مقاومت فوق العاده فیلها در برابر سرطان با وجود اندام بزرگ را کشف کردند. به گفته آنها این پستاندار دارای کپیهای بسیار زیاد ...
![]() ۲۰ بهمن ۱۳۹۹
۲۰ بهمن ۱۳۹۹
-
علمی دانشمندان چینی با روش ژن درمانی پیری را به تاخیر میاندازند
دانشمندان چینی موفق به کشف روش جدید ژن درمانی شدهاند که میتواند پیری را در موشها معکوس کرده و حتی طول عمر آنها را افزایش ...
![]() ۱ بهمن ۱۳۹۹
۱ بهمن ۱۳۹۹
-
علمی محققان با موفقیت دادهها را درون DNA باکتری زنده ذخیره کردند
DNA به لطف تراکم فوق العاده بالا قادر به ذخیرهسازی دادهها در قالب حدود ۱۰ فیلم در حجمی به اندازه یک دانه نمک است. حال ...
![]() ۲۴ دی ۱۳۹۹
۲۴ دی ۱۳۹۹
-
علمی نتیجه پژوهشی جدید: دوقلوهای همسان از نظر ژنتیکی کاملا یکسان نیستند
پژوهشی جدید نشان میدهد که تفاوتهای ژنتیکی میان دوقلوهای همسان میتواند در مراحل اولیه رشد جنینی آغاز شود و آنها از نظر ژنتیکی با یکدیگر ...
![]() ۲۱ دی ۱۳۹۹
۲۱ دی ۱۳۹۹
-
علمی پژوهشگران موفق به کنترل عملکردهای DNA با استفاده از نور شدند
DNA اساسیترین عنصر سازنده حیات روی زمین محسوب میشود که تمام اطلاعات ژنتیکی موردنیاز برای عملکرد، رشد و تولید مثل ارگانیسمها در آن ذخیره میشوند. ...
![]() ۱۵ دی ۱۳۹۹
۱۵ دی ۱۳۹۹
-
علمی سالم ترین مومیایی گرگ با ۵۷ هزار سال قدمت در کانادا کشف شد
یک معدنچی طلا در کانادا به طور تصادفی کاملترین مومیایی گرگ تا به امروز را پیدا کرد. این جاندار ۵۷ هزار سال پیش در لایه ...
![]() ۳ دی ۱۳۹۹
۳ دی ۱۳۹۹

همچنین میتوانید جهت آگاهی از آخرین اخبار در حوزه تکنولوژی و اطلاع از بروزرسانی دیجیاتو مارا در شبکههای اجتماعی زیر نیز دنبال کنید. خوشحالیم که همراه ما هستید.